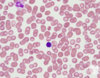
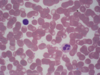

Hematology cell recognition - Random Flashcards
(41 cards)

Neutrophilic band

basophilic normoblast in the middle

neutrophilic band, toxic granulation (caused by infection)

Megakaryocyte in the bone marrow

2 neutrophilic band cells with Döhle bodies (caused by infection)

two basophilic normoblasts in the middle

megaloblastic anemia bone marrow: erythroid hyperplasia, lots of megaloblasts, karyorrhexis, Howell-Jolly body

eo. segment

proerythroblast in the middle, intermed. normoblasts to the right

Basophilic granulocyte

top right: monocyte, the rest of the cells are neutr.
** Not sure about the upper right
Lymphocyte in the middle, neutrophilic segment at the top

multiplex myeloma bone marrow: many plasma cells

Platelets

2 lymphocytes, the upper is LGL (large granulated lymphocyte: NK or T killer)

neutrophilic myelocyte

Eosinophilic segment

multiplex myeloma bone marrow: many plasma cells

Hypersegmented neutrophil

myeloblast in the middle

proerythroblast in the middle

acute leukemia bone marrow: many blasts
lymphocyte on the left, neutr. segment on the right

neutrophilic segment



















